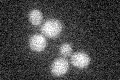
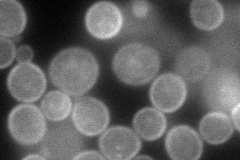
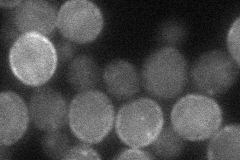

View description
Transporter of the ATP-binding cassette family, involved in uptake of sterols and anaerobic growth
Localization:
Intensity:
Fold change:
Significance:
-
C’ GFP library in SD
below threshold15.92 -
N' NOP1pr-GFP in SD
cell periphery,ER123.318 -
N' TEF2pr-mCherry in SD

cell periphery,vacuole119.606 -
N' NATIVEpr-GFP in SD

below threshold19.1993 -
N' TEF2pr-VC and Cyto-VN in SD
cell periphery,punctate44.0652 -
C’ GFP library in SD+DTT

cytosol15.910.99No -
C’ GFP library in SD+H2O2

cytosol15.850.99No -
C’ GFP library in Starvation Media

cytosol16.311.02No -
C’ GFP library on the background of Pup2-DaMP

below threshold -
C’ GFP library on the background of CCT mutant

below threshold14.08780.884859No
